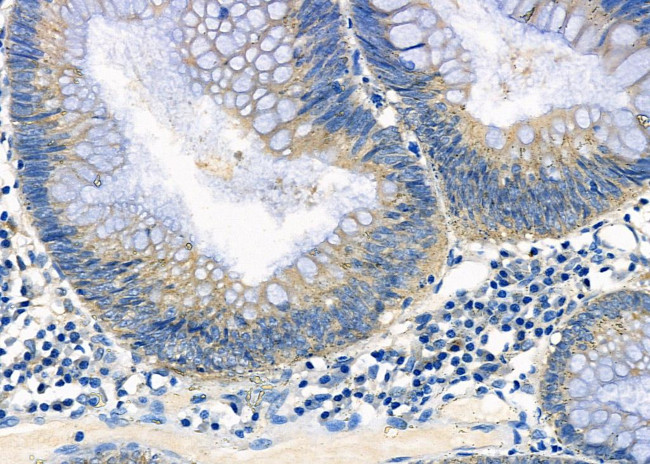
ATIC Antibody in Immunohistochemistry (Paraffin) (IHC (P))

Search
Invitrogen
ATIC Polyclonal Antibody
{{$productOrderCtrl.translations['antibody.pdp.commerceCard.promotion.promotions']}}
{{$productOrderCtrl.translations['antibody.pdp.commerceCard.promotion.viewpromo']}}
{{$productOrderCtrl.translations['antibody.pdp.commerceCard.promotion.promocode']}}: {{promo.promoCode}} {{promo.promoTitle}} {{promo.promoDescription}}. {{$productOrderCtrl.translations['antibody.pdp.commerceCard.promotion.learnmore']}}
图: 1 / 5
ATIC Antibody (PA5-106931) in IHC (P)





产品信息
PA5-106931
种属反应
宿主/亚型
分类
类型
抗原
偶联物
形式
浓度
规格
纯化类型
保存液
内含物
保存条件
运输条件
RRID
产品详细信息
Antibody detects endogenous levels of total ATIC.
靶标信息
ATIC is a 5-aminoimidazole-4-carboxamide ribonucleotide formyltransferase which helps catalyze the penultimate and final steps of the de novo purine biosynthetic pathway. The human ATIC cDNA encodes a deduced 591-amino acid protein that is 81% identical to the chicken sequence.
仅用于科研。不用于诊断过程。未经明确授权不得转售。
篇参考文献 (0)
生物信息学
蛋白别名: 5-aminoimidazole-4-carboxamide-1-beta-D-ribonucleotide transformylase/inosinicase; AICAR formyltransferase/IMP cyclohydrolase bifunctional enzyme; AICAR transformylase/inosine monophosphate cyclohydrolase; AICARFT/IMPCHASE; ATIC; Bifunctional purine biosynthesis protein ATIC; bifunctional purine biosynthesis protein PURH; epididymis secretory sperm binding protein Li 70p; phosphoribosylaminoimidazolecarboxamide formyltransferase/IMP cyclohydrolase; unnamed protein product
基因别名: 2610509C24Rik; AA536954; AICAR; AICARFT; ATIC; AW212393; HEL-S-70p; IMPCHASE; OK/SW-cl.86; PURH
UniProt ID: (Human) P31939, (Rat) O35567, (Mouse) Q9CWJ9
Entrez Gene ID: (Human) 471, (Rat) 81643, (Mouse) 108147